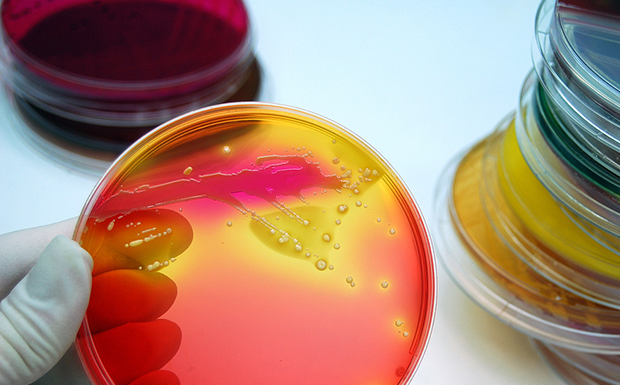
Antibiotics

Home > Products > Biochemical Reagents > Biology Chemical

Chemical biology is the science that studies the chemical basis of life processes. The occurrence and development of diseases are the interference and disruption of life processes by pathogenic factors; drug prevention and treatment are interventions in pathological processes.
We provide high-quality chemical biology products such as biological buffer solutions, agarose, antibiotics, carbohydrates, chelating agents, reducing agents, and vitamins.
We provide high-quality chemical biology products such as biological buffer solutions, agarose, antibiotics, carbohydrates, chelating agents, reducing agents, and vitamins.
Explore by Category

Agarose
Agarose is a polysaccharide extracted from seaweed, primarily made from agar powder, and possesses gelling and thickening properties. It is widely used in food, pharmaceuticals, cosmetics, and biotechnology.
High-quality agarose products offered by Howei can be used for the separation of DNA and proteins. Its characteristics include high gel strength, low solidification temperature, and good transparency.
High-quality agarose products offered by Howei can be used for the separation of DNA and proteins. Its characteristics include high gel strength, low solidification temperature, and good transparency.

Natural Products
Natural products refer to products whose main ingredients are derived from nature (such as plants, minerals, or animals), whose production process strictly limits the use of synthetic additives, chemicals, and genetically modified technologies, and which have passed authoritative certification systems. These products cover fields such as food, cosmetics, and health supplements. Their core lies in the naturalness of the raw materials, the environmental friendliness of the production process, and the reliability of the certification.
Explore more Categories
Biological Buffers
Biological buffers play a crucial role in biological experiments by regulating pH and protecting the activity of biomolecules. Howei offers a broad portfolio of biological buffer products for various applications, including cell culture buffers, PCR buffers, HEPES buffers, and assay buffers.
Antibiotics
The use of antibiotics in cell culture can prevent pathogens from contaminating cells, inducing morphological or physiological changes during cell culture, and preventing cell line contamination. Antibiotics, such as penicillin, fosfomycin, and ampicillin, specifically target and kill cells by inhibiting or regulating cell wall synthesis, nucleic acid metabolism, and protein synthesis, or by disrupting membrane structures.
Carbohydrates
Carbohydrates are organic compounds composed of carbon, hydrogen, and oxygen. Their chemical structure consists of aldehydes or ketones with multiple hydroxyl groups and their derivatives or polymers. They provide more than 2,000 high-quality products such as glucose, fructose, galactose, and maltose.
Chelating Reducing Agents
Chelating agents are compounds that can form complexes with metal ions. They contain two or more ligands that react with the metal ions to form stable complexes. Chelating agents typically contain multiple quaternary ammonium groups, amino groups, and other functional groups, which can tightly encapsulate the metal ions within the molecule, reducing the catalytic activity of the metal ions and preventing their environmental impact.
They are widely used in pharmaceuticals, cosmetics, and food to adjust pH and promote stability.
Coenzymes
Coenzymes are small organic molecules that can transfer chemical groups from one enzyme to another. They bind loosely to enzymes and are essential for the activity of specific enzymes. Coenzyme products provided by Howei assist in energy coupling reactions within cells, act as carriers of hydrogen atoms, electrons, or chemical groups, and promote reactions by binding to enzyme substrates at the enzyme's active site.
Detergents
Detergents are surfactants or compounds that reduce the surface tension between two liquids or between a liquid and a solid by dissolving hydrophobic molecules. These water-soluble surfactants consist of a hydrophobic moiety (usually a long alkyl chain) and hydrophilic or water-soluble functional groups. Detergents are commonly used in biochemistry, cell biology, and molecular biology for cell lysis, purification of membrane proteins and lipids, protein crystallization, and reducing background staining in blot experiments.
Nucleosides & Nucleotides
Nucleosides are a general term for a class of glycosides. They are components of nucleic acids and nucleotides. Nucleosides are formed by the condensation of D-ribose or D-Z-deoxyribose with pyrimidine or purine bases. Nucleosides are generally colorless crystals, insoluble in common organic solvents, but readily soluble in hot water.
Nucleosides can be prepared by hydrolyzing nucleic acids. Ribonucleotides can be obtained by hydrolyzing RNA with pyridine aqueous solution, alumina, or enzymatic hydrolysis; deoxyribonucleotides can be obtained by hydrolyzing DNA with alumina or enzymatic hydrolysis.
Vitamins
Vitamins are a class of organic compounds essential for maintaining good health. These substances are neither building blocks of body tissues nor sources of energy, but rather regulatory agents that play a vital role in metabolism.
We offer a wide range of vitamin research products, mixtures, and kits. Our products are of high purity, ensuring consistency, reliability, and quality in your life science research.
Culture Medium
Culture medium is a nutrient substrate composed of different nutrients, designed to support the growth and reproduction of microorganisms, plants, or animals (or tissues). It generally contains several major categories of substances, including carbohydrates, nitrogenous substances, inorganic salts (including trace elements), vitamins, and water. Culture medium is not only the basic substance providing cell nutrition and promoting cell proliferation, but also the living environment for cell growth and reproduction.
Selecting Products Filters
-
Product No.Product NameProduct Spec.BrandPrice